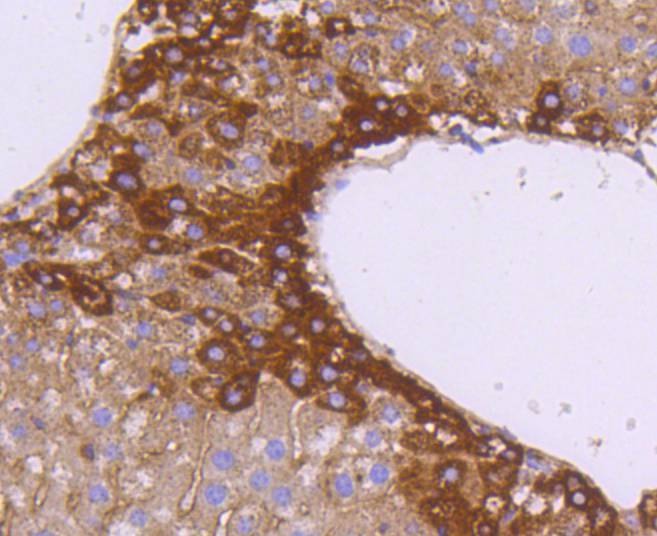
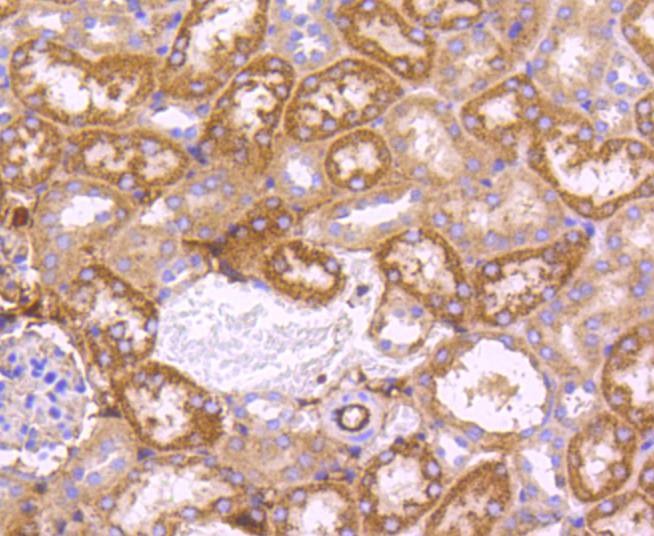

您的购物车当前为空
您的购物车当前为空
Anti-SGK1 Antibody (8M491)
Synonyms: SGK1_HUMAN, Sgk1 variant i3, SGK 1, SGK, Serum/glucocorticoid-regulated kinase 1, Serum/glucocorticoid regulated kinase 1, Serum/glucocorticoid regulated kinase, Serum and glucocorticoid regulated kinase, Serine/threonine-protein kinase Sgk1, Serine/threonine protein kinase Sgk1, Serine/threonine protein kinase SGK, OTTHUMP00000017247货号 TMAC-03727 一键复制产品信息
Anti-SGK1 Antibody (8M491) 是一种 Rabbit 抗体,靶向 SGK1。Anti-SGK1 Antibody (8M491) 可用于 FCM,IHC,IP,WB。
Anti-SGK1 Antibody (8M491)
一键复制产品信息货号 TMAC-03727
别名 SGK1_HUMAN, Sgk1 variant i3, SGK 1, SGK, Serum/glucocorticoid-regulated kinase 1, Serum/glucocorticoid regulated kinase 1, Serum/glucocorticoid regulated kinase, Serum and glucocorticoid regulated kinase, Serine/threonine-protein kinase Sgk1, Serine/threonine protein kinase Sgk1, Serine/threonine protein kinase SGK, OTTHUMP00000017247
Anti-SGK1 Antibody (8M491) 是一种 Rabbit 抗体,靶向 SGK1。Anti-SGK1 Antibody (8M491) 可用于 FCM,IHC,IP,WB。
Anti-SGK1 Antibody (8M491)
| 规格 | 价格 | 库存 | 数量 |
|---|---|---|---|
| 50 μL | ¥ 1,490 | 5日内发货 | |
| 100 μL | ¥ 2,495 | 5日内发货 |
库存状态实时更新,以官网显示为准,现货产品可直接加购物车下单
大包装 & 定制
加入购物车
TargetMol的所有产品仅用作科学研究或药证申报,不能被用于人体,我们不向个人提供产品和服务。请您遵守承诺用途,不得违反法律法规规定用于任何其他用途。
资源下载:产品操作手册
产品介绍
生物活性
偶联与修饰
抗原信息
化学信息
储存&溶解度
| 产品描述 | Anti-SGK1 Antibody (8M491) is a Rabbit antibody targeting SGK1. Anti-SGK1 Antibody (8M491) can be used in FCM,IHC,IP,WB. |
| 别名 | SGK1_HUMAN, Sgk1 variant i3, SGK 1, SGK, Serum/glucocorticoid-regulated kinase 1, Serum/glucocorticoid regulated kinase 1, Serum/glucocorticoid regulated kinase, Serum and glucocorticoid regulated kinase, Serine/threonine-protein kinase Sgk1, Serine/threonine protein kinase Sgk1, Serine/threonine protein kinase SGK, OTTHUMP00000017247 |
| Ig Type | IgG |
| 克隆号 | 8M491 |
| 反应种属 | Human,Mouse,Rat |
| 验证活性 | 1. Western blot analysis of SGK1 on human kidney lysates using anti-SGK1 antibody at 1/1,000 dilution. 2. Immunohistochemical analysis of paraffin-embedded human liver tissue using anti-SGK1 antibody. Counter stained with hematoxylin. 3. Immunohistochemical analysis of paraffin-embedded human kidney tissue using anti-SGK1 antibody. Counter stained with hematoxylin. 4. Immunohistochemical analysis of paraffin-embedded mouse liver tissue using anti-SGK1 antibody. Counter stained with hematoxylin. 5. Immunohistochemical analysis of paraffin-embedded mouse brain tissue using anti-SGK1 antibody. Counter stained with hematoxylin. 6. Immunohistochemical analysis of paraffin-embedded mouse kidney tissue using anti-SGK1 antibody. Counter stained with hematoxylin. 7. Flow cytometric analysis of 293 cells with SGK1 antibody at 1/50 dilution (red) compared with an unlabelled control (cells without incubation with primary antibody; black). Alexa Fluor 488-conjugated goat anti rabbit IgG was used as the secondary antibody. |
| 应用 | FCMIHCIPWB |
| 推荐剂量 | WB: 1:1000; IHC: 1:50-200; FCM: 1:50-100 |
| 抗体种类 | Monoclonal |
| 宿主来源 | Rabbit |
| 构建方式 | Recombinant Antibody |
| 纯化方式 | ProA affinity purified |
| 性状 | Liquid |
| 缓冲液 | 1*TBS (pH7.4), 1%BSA, 40%Glycerol. Preservative: 0.05% Sodium Azide. |
| 研究背景 | Serum- and glucocorticoid-regulated kinase (SGK), also known as SGK1, is a serine/threonine protein kinase and a member of the "AGC" subfamily, which includes protein kinases A, G, and C. SGK plays an important role in activating certain potassium, sodium, and chloride channels, suggesting an involvement in the regulation of processes such as cell survival, neuronal excitability, and renal sodium excretion. SGK contains a catalytic domain, which is most similar to Akt1 (also known as protein kinase B or PKB). SGK is a downstream target of PI 3-kinase-stimulated growth factor signaling, with 3-phosphoinositide-dependent protein kinase 1 (PDK1) capable of phosphorylating the activation-loop of SGK at Threonine-256. The adrenal corticosteroid hormone, Aldosterone, induces the transcription of SGK, which mediates Na + transport by stimulating epithelial sodium channel activity. The SGK promoter contains a glucocorticoid response element and an SP-1 regulatory element, and is a transcriptional target for p53. SGK is also a component of the p38 MAPK-mediated response to hyperosmotic stress. The human SGK gene maps to chromosome 6q23 and encodes the 431-amino acid SGK protein. |
| 偶联 | Unconjugated |
| 免疫原 | Recombinant Protein |
| Uniprot ID |
| 分子量 | Theoretical: 55 kDa. |
| 储存方式 | Store at -20°C or -80°C for 12 months. Avoid repeated freeze-thaw cycles. |
| 运输方式 | Shipping with blue ice. |
计算器
Related Tags: buy Anti-SGK1 Antibody (8M491) | purchase Anti-SGK1 Antibody (8M491) | Anti-SGK1 Antibody (8M491) cost | order Anti-SGK1 Antibody (8M491) | Anti-SGK1 Antibody (8M491) molecular weight





 还可以
还可以
 |
|